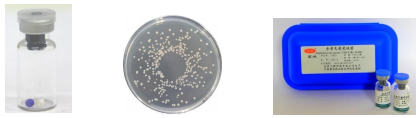
产品封面图

相关产品推荐更多 >
万千商家帮你免费找货
0 人在求购买到急需产品
- 详细信息
- 询价记录
- 文献和实验
- 技术资料
风险提示:丁香通仅作为第三方平台,为商家信息发布提供平台空间。用户咨询产品时请注意保护个人信息及财产安全,合理判断,谨慎选购商品,商家和用户对交易行为负责。对于医疗器械类产品,请先查证核实企业经营资质和医疗器械产品注册证情况。
- 作者
- 内容
- 询问日期
文献和实验佚名 1963年Blumberq在两名多次接受输血治疗的病人血清中,发现一种异常的抗体,它能与一名澳大利亚土著人的血清起沉淀反应。直到1967年才明确这种抗原与乙型肝炎(简称乙肝)有关,1970年在电子显微镜下观察到HBV的形态,1986年将其列入嗜肝DNA病毒科。 一、生物学性状 (一)形态与结构 1.大球
佚名 本病毒首先(1953年)在日本从患者脑组织中分离获得,因此称日本脑炎病毒(Japanese encephalitis virus ,JEV),所致疾病在日本称日本乙型脑炎(JBE)。1950年以来,我国对该病进行了大量病原学和流行病学研究,为了与甲型脑炎相区别,定名为流行性乙型脑炎,简称乙脑,是我国夏秋季流行的主要传染病之一,除新疆、西藏
庄辉 苏盛 朱立平 任芙蓉 乙型肝炎表面抗原(HBsAg)胶体金试剂系用2株小鼠抗HBsAg不同表位的单克隆抗体,一株用胶体金标记,并固定在玻璃纤维素膜上;另一株包被硝基纤维素膜作为固相。然后,将该两种膜分别粘贴在双面胶白色塑料垫板上,制成试纸条。其原理是用双抗体夹心法检测血清中HBsAg。血清中HBsAg先与胶体金标记的抗-HBs单克隆抗体起反应,然后再与包被于硝基纤维素膜上的抗-HBs单克隆抗体作用,并在该处显示紫红色条带。其具体检测方法如下:首先将可拆微量反应板固定
技术资料暂无技术资料 索取技术资料